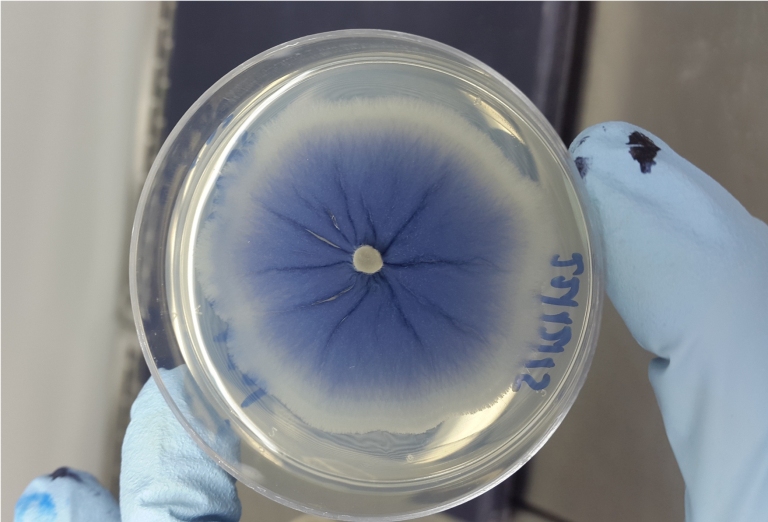

Fungos contra a dengue
Pesquisadores da Universidade Federal de Minas Gerais (UFMG) e da Fundação Oswaldo Cruz (Fiocruz) identificaram em fungos na Antártica duas substâncias com potencial para dar origem a medicamentos antivirais.
As substâncias se mostraram capazes de inibir o vírus da dengue, embora mais estudos sejam necessários para diminuir a toxicidade do fármaco.
E estes são apenas os primeiros resultados da expedição Micologia Antártica (MycoAntar), que está realizando testes com mais de 5 mil extratos de substâncias obtidas durante as expedições. As amostras, reunidas desde a criação do projeto, em 2013, permitiu à UFMG constituir a maior coleção de fungos da Antártica do mundo. São cerca de 8 mil espécies.
A partir dessas amostras, os fungos são cultivados em baixa temperatura e os extratos coletados são enviados para o Centro de Pesquisa Renê Rachou, da Fiocruz, onde foram identificados aqueles que manifestaram atividade biológica em contato com o vírus da dengue.
"Digamos que, de mil extratos, 100 foram ativos. Então, vamos mapear cada substância desses 100 extratos para testá-las individualmente. Já estamos nessa fase do estudo. Dois extratos já se mostraram mais promissores e agora vamos caracterizar todas as suas substâncias," explicou Luiz Rosa, pesquisador da UFMG.
Meleagrina
A equipe já identificou uma substância capaz de inibir o vírus da dengue, conhecida como meleagrina. No entanto, ela não é inédita.
"Já havia sido observada em fungo marinho e agora nós a encontramos em um fungo da Antártica. O problema é o seu preço. Apenas 1 miligrama vale US$ 1 mil. Mas pode ser que, de repente, nós descobrimos que esse fungo consegue produzi-la em maior quantidade. Ou quem sabe, no futuro, a gente consiga usar essa substância como modelo para criar uma molécula sintética que pode gerar um medicamento acessível", acrescentou Luiz Rosa.
Um eventual medicamento promissor não precisará necessariamente ser capaz de eliminar a dengue por completo. Pode ser, por exemplo, um remédio que alivie os sintomas de uma fase aguda ou que ajude a desenvolver uma vacina.
Os estudos com foco na busca por medicamentos contra a dengue estão mais avançados, mas também está sendo verificada a atividade das substâncias coletadas para os vírus zika e da febre chikungunya, entre outras doenças.

Biodiversidade microbiana
A Antártica é 1,6 vez maior que o Brasil e 1,4 vez maior que os Estados Unidos. Em toda essa extensão há uma grande variedade de seres vivos. No entanto, a vida do continente gelado é composta de poucos macrorganismos. A maior biodiversidade é microbiana, isto é, composta de bactérias, fungos, vírus, microalgas etc.
O isolamento da Antártica também faz com que muitas dessas espécies tenham características particulares e sejam exclusivas, não existindo em qualquer outra parte do mundo.
"Este ano nós descrevemos um fungo novo, azul, o que é muito raro. Então estas espécies que existem lá podem ter vias metabólicas únicas, o que pode levar à descoberta de substâncias inéditas," esclareceu Luiz Rosa. A nova espécie foi encontrada na neve da Antártica e foi batizada de Antarctomyces pellizariae.
Infelizmente existe também a preocupação inversa, com organismos que possam causar danos aos seres humanos ou animais. Ambientalistas têm alertado que o degelo nas áreas polares pode liberar microrganismos que estão congelados há milhares de anos, aos quais a raça humana pode não ter sido exposta anteriormente e, portanto, não possuir defesas. Atualmente o degelo prossegue forte no Ártico, mas a cobertura de gelo da Antártica vem-se ampliando.
| Ver mais notícias sobre os temas: | |||
Medicamentos Naturais | Plantas Medicinais | Desenvolvimento de Medicamentos | |
| Ver todos os temas >> | |||
A informação disponível neste site é estritamente jornalística, não substituindo o parecer médico profissional. Sempre consulte o seu médico sobre qualquer assunto relativo à sua saúde e aos seus tratamentos e medicamentos.
Copyright 2006-2026 www.diariodasaude.com.br. Todos os direitos reservados para os respectivos detentores das marcas. Reprodução proibida.